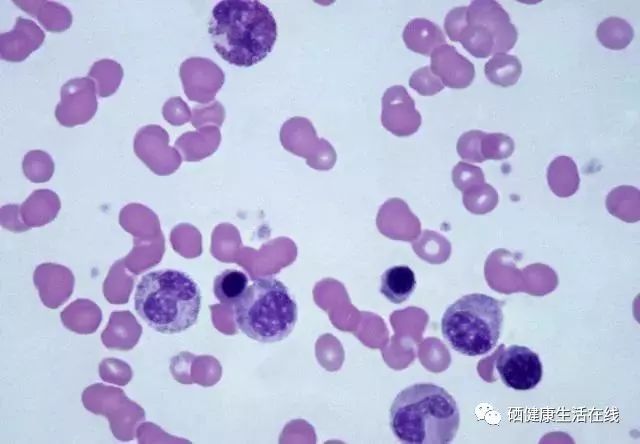
癌症是不是不能补硒（癌症能补是硒元素吗）-硒宝网

癌症是不是不能补硒(癌症能补是硒元素吗)
点击上方「硒健康生活在线」关注我们
硒进入血液,与红细胞的血红蛋白和血浆中的白蛋白或α球蛋白结合,通过血浆运载,输送到各组织器官。首先分布到血液供给量丰富的地方,血液供应越丰富的器官,分布越多,随后按器官与硒的亲和力有选择地再分布。硒主要分布到肝、肾和生殖腺,其次是血、脾、心、肌肉、胰、肺、脑、骨及消化道。人体的消化道、呼吸道、皮肤、皮下、肌肉或静脉都可以吸收硒。十二指肠是一些硒吸收的主要部位。

首先,适当的补硒能降低癌症的发病率,抑制癌细胞生长扩散、减轻放化疗副作用,还能减少化疗药物的毒性。研究显示,在化疗前后服用较大剂量硒,可以减少白细胞降低,恶心、呕吐、食欲减退、严重脱发、肾毒性等副作用,从而有助于合理加大化疗药物的剂量,以取得更好疗效。
在微量元素的研究中,有些元素的生物学半减期是非常长的,锶约为40年,镉为20年以上,说明一经吸收后是很难排出的。
测定硒在体内留存的方法,观察到硒在人体内的半减期。肿瘤为中硒的生物学半减期为70天,肝脏50天,肾脏32天,血清为28天,这是4例供试者的实验结果。都是以“天”计算的,说明硒能够不断被人体吸收,同时也会不断排出,说明人体需要不断地补充硒元素。

但是补硒是需要适量的,超过每天所需要的量也会造成身体的不适,国内补硒提倡采用安全性高的有机硒。
01
何时发现硒是人体必需的微量元素?
1973年联合国卫生组织宣布硒是动物生命中必需的微量元素;1988年中国营养学会将硒列为15种人体必需的微量元素,1994年卫生部将硒列为食品营养强化剂;2003年美国食品药品管理局(FDA)批准一项重大决议:认可硒为抑癌剂。
目前硒已成为全世界抗癌保肝、解毒、抗衰老的营养元素。
02
硒的十大功效是什么?
(1)抗氧化、抗衰老(生命之光)
(2)?;?、修复、活化细胞,有助于提高机体免疫力(生命之光)
(3)解毒、排毒、抗辐射(天然解毒剂)
(4)有助于抑制肿瘤(抗癌之王)
(5)?;ば哪匝埽ㄐ脑嗟谋;ど瘢?/p>
(6)?;じ卧啵ǜ尾〉奶斓校?/p>
(7)帮助恢复胰岛功能(微量元素中的胰岛素)
(8)改善视力(明亮的使者)
(9)提升生殖系统功能(生命的天使)
(10)在防治风湿骨痛、呼吸、胃肠道疾病等方面发挥着重要的生物学功效。
03
中国人缺硒的原因是什么?
缺硒的主要原因有五种:
(1)环境缺硒。我国有72%的国土硒含量低于平均水平,其中30%为严重缺硒地区,长期生活在严重缺硒地区的人易患克山病等地方病。

(2)环境污染。农药、化肥、冶炼、印染导致的有害残留物会拮抗硒的吸收,造成缺硒。
(3)主食过于精细,粗粮太少。饮食结构不合理硒摄入不足导致营养性缺硒。
(4)烟酒不节制。烟草中有害重金属镉及致癌有机化合物均能拮抗硒的吸收;酗酒伤肝,致使肝脏中硒元素过多代谢而缺硒。
(5)中老年人吸收机能下降,硒摄入不足而缺硒。
04
哪些人群需要补硒?
只要你不是长期生活在富硒地区,无论你的身体健康与否都应当适量补硒,尤其是以下人群,更应科学补硒:
心血管病人;肿瘤患者;糖尿病患者;慢性肝病患者;胃肠道疾病患者;哮喘等呼吸道疾病患者;视力减退、青光眼、白内障等眼病患者;生殖系统疾病患者及不孕不育者;从事有毒有害工作者;亚健康人群;渴望长寿的中老年人等。
05
人体中硒的来源和日需量是多少?

中国营养学会推荐正常成年人每天的硒摄入量为50-250微克。长期低于50微克容易患克山病等地方病,以及肿瘤、肝病、心脑血管疾病等。人们可以从日常的食物中获取硒,但不能达到中国营养学会规定的日常最低需求量50微克,所以需额外补充硒制剂。

欢迎“写留言”,交流互动
